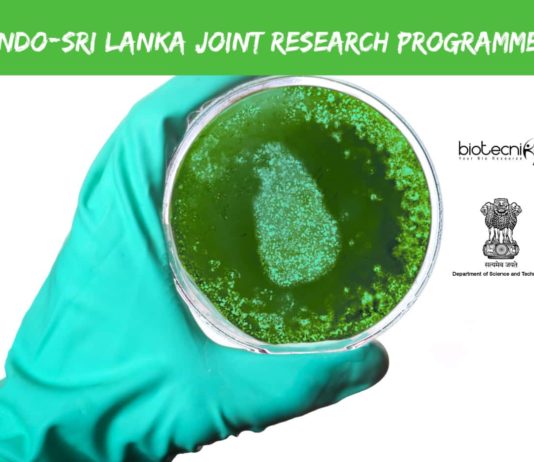
Indo-Sri Lanka Food Tech

Anjani Mashelkar, Dr R. A. Mashelkar's mother, brought him up facing all the odds that a poor widowed uneducated mother moving to Mumbai with...
Australian Government Research Training
Australian Government Research Training Program (AGRTP) Scholarship (International) notification has been released. This is open to Bachelor's, Master's and Doctoral candidates...
Apply For Kerela Biotechnology Re-Entry Fellowship ( KBIREF ) Under KBC
Kerela Biotechnology Re-Entry Fellowship ( KBIREF )
Objective :
The aim of this senior level fellowship...
ASM-IUSSTF INDO-US Professorship In Microbiology 2019
The official notification for the ASM-IUSSTF INDO-US Professorship In Microbiology 2019 has been announced. Visiting Teaching & Research Professorship In Microbiology...
RAMAN–CHARPAK FELLOWSHIP 2017
Call for Applications
for
Indian & French PhD Students
The Raman–Charpak Fellowship program is in honour of two Nobel Laureates in Physics, Prof C.V. Raman,...
Reliance Foundation Postgraduate Scholarships 2025-26 For Life Sciences
Reliance Foundation Scholarships 2025-26 For Life Sciences Postgraduate. Scholarship Value of Up to Rs. 6 Lakh. 100...
Department of Science & Technology
Government of India
Announcement 2017
Project- based Personnel Exchange Programme with India
- Indo-German Joint Research Collaboration -
DAAD / Department of Science and...
SRISTI celebrates the creativity and innovation of young technological students by recognising their outstanding projects with Gandhian Young Technological Innovation (GYTI) Awards. These awards...
EMBO Young Investigator Programme 2020 - Applications Invited
EMBO Young Investigator Programme 2020 - Applications Invited. EMBO Funding & Awards - Young Investigator Program 2020....
SERB-POWER Grant 2022 - Applications Invited From Women Researchers
SERB - POWER (Promoting Opportunities For Women in Exploratory Research) program is formulated to mitigate gender...
Prime Minister PhD Fellowship - PM Fellowship Notification
Notification for the Prime Minister PhD Fellowship has been released. Applicants can apply for it as it...
Vienna BioCenter Summer School 2025 - 9-week Research Program for Life Science Undergrads at one of Europe's leading Research Centers
Summer 2025 Call Now Open
Deadline...
INSPIRE SHE 2024, Scheme Scholarship for Higher Education | Get Scholarship + Mentorship Grant, Applications Open
INSPIRE SHE 2024, Scheme Scholarship for Higher Education |...
Indo-Australia Early and Mid-Career Researchers (EMCR) Fellowship Programme 2016-2017
Administered by Indian National Science Academy, New Delhi
Supported by Department of Science & Technology,...
Apply For The Famous EMBO Short-Term Fellowships
EMBO is an organization of more than 1700 leading researchers that promotes excellence in the life sciences. The...